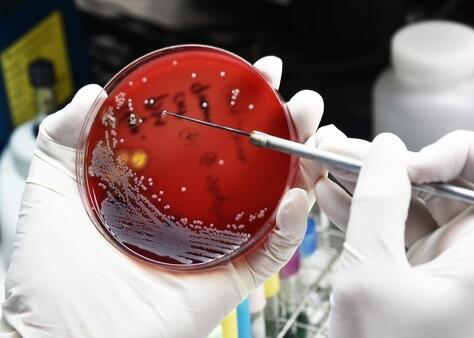
脐带血干细胞产品致12人发生严重感染，美CDC及FDA已介入调查

昨日(12月27日),信达生物的PD-1单克隆抗体信迪利单抗注射液(商品名:达伯舒)正式被国家药品监督管理局批准上市,用于治疗至少经过二线系统化疗的复发或难治性经典型霍奇金...
2018-12-27 21:43

日前,EvaluatePharma发布了2018年全球药企销售额及预测涨幅数据,榜单显示,默沙东明星产品Keytruda以及艾伯维丙型肝炎药物Mavyret的销售业绩和未来预期良好,而其他丙肝药品的...
文/范东东 2018-12-27 17:53

在前任董事长去世后,鲁南制药持续的“内斗”已经让其站到了十字路口,“现在最大的问题,是没有一个能够控制公司的大股东”。《每日经济新闻》记者调查获悉,占鲁南制药销售额...
文/彭斐 2018-12-27 16:01

国家发展改革委、商务部日前印发《市场准入负面清单(2018年版)》。12月25日上午,国家发展改革委举行新闻发布会介绍《市场准入负面清单(2018年版)》有关情况。对比旧版清单...
文/李蕴明 2018-12-27 15:48

就在关于百亿保健帝国权健的话题持续发酵的当头,昨日(12月26日),市场监管总局发布关于进一步加强保健食品生产经营企业电话营销行为管理的公告指出:保健食品生产经营企业要...
2018-12-27 15:37

“4+7带量采购”撕开市场变局,价格战一触即发,在扬子江接连突袭之后,恒瑞以净利润下滑亿元的代价主动出手狙击,谁能赢?
文/TEDY 2018-12-27 13:32
本次事件中的脐带血干细胞产品是由Genetech生产、Liveyon分销的,感染的为大肠杆菌、粪肠球菌和奇异变形杆菌。
文/周会棋(编译) 2018-12-27 11:17

近日,苏州晶云药物科技股份有限公司(以下简称“晶云药物”)宣布完成超过1亿元人民币的B轮融资。本轮融资由拾玉领投,同创伟业和元禾原点跟投,此前,晶云药物曾于2015年9月完...
2018-12-26 16:44